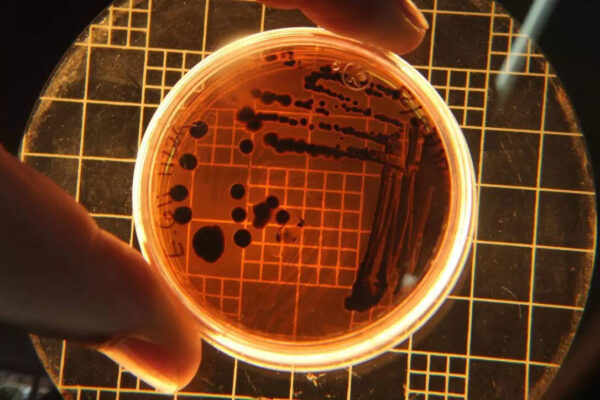

Pisces Daily Horoscope October 30, 2025: Navigating Transitions Between Endings and Beginnings
The daily Pisces horoscope for October 30, 2025, highlights a significant period of transition as individuals born under this sign move through a doorway between endings and beginnings. The forecast encourages Pisces to embrace change with openness, focusing on personal growth and new opportunities. Discover the Pisces daily horoscope for October 30, 2025. Learn how…